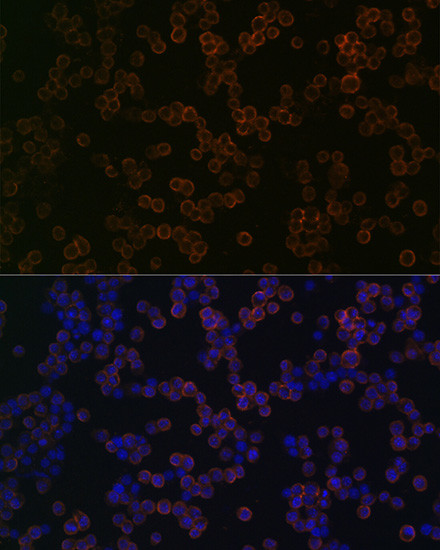
TLR2 Antibody in Immunocytochemistry (ICC/IF)

Search
Invitrogen
TLR2 Recombinant Rabbit Monoclonal Antibody (8Q6M9)
{{$productOrderCtrl.translations['antibody.pdp.commerceCard.promotion.promotions']}}
{{$productOrderCtrl.translations['antibody.pdp.commerceCard.promotion.viewpromo']}}
{{$productOrderCtrl.translations['antibody.pdp.commerceCard.promotion.promocode']}}: {{promo.promoCode}} {{promo.promoTitle}} {{promo.promoDescription}}. {{$productOrderCtrl.translations['antibody.pdp.commerceCard.promotion.learnmore']}}


Please note: We are reviewing Western blot images included in the antibody testing data in our catalog, including those provided by third parties. Unless expressly labeled or annotated as “raw-unedited”, Western blot images included in the antibody testing data in our catalog may have been edited, optimized or otherwise adjusted for presentation.
产品信息
MA5-35274
种属反应
宿主/亚型
Expression System
分类
类型
克隆号
抗原
偶联物
形式
浓度
规格
纯化类型
保存液
内含物
保存条件
运输条件
RRID
产品详细信息
Immunogen sequence: MPHTLWMVWV LGVIISLSKE ESSNQASLSC DRNGICKGSS GSLNSIPSGL TEAVKSLDLS NNRITYISNS DLQRCVNLQA LVLTSNGINT IEEDSFSSLG SLEHLDLSYN YLSNLSSSWF KPLSSLTFLN LLGNPYKTLG ETSLFSHLTK LQILRVGNMD TFTKIQRKDF AGLTFLEELE IDASDLQSYE PKSLKSIQNV SHLILHMKQH ILLLEIFVDV TSSVECLELR DTDLDTFHFS ELSTGETNSL IKKFTFRNVK ITDESLFQVM KLLNQISGLL ELEFDDCTLN GVGNFRASDN DRVIDPGKVE TLTIRRLHIP RFYLFYDLST LYSLTERVKR ITVENSKVFL VPCLLSQHLK SLEYLDLSEN LMVEEYLKNS ACEDAWPSLQ TLILRQNHLA SLEKTGETLL TLKNLTNIDI SKNSFHSMPE TCQWPEKMKY LNLSSTRIHS VTGCIPKTLE ILDVSNNNLN LFSLNLPQLK ELYISRNKLM TLPDASLLPM LLVLKISRNA ITTFSKEQLD SFHTLKTLEA GGNNFICSCE FLSFTQEQQA LAKVLIDWPA NYLCDSPSHV RGQQVQDVRL SVSECHRTAL VSGMCCALFL LILLTGVLCH RFHGLWYMKM MWAWLQAKRK PRKAPSRNIC YDAFVSYSER DAYWVENLMV QELENFNPPF KLCLHKRDFI PGKWIIDNII DSIEKSHKTV FVLSENFVKS EWCKYELDFS HFRLFDENND AAILILLEPI EKKAIPQRFC KLRKIMNTKT YLEWPMDEAQ REGFWVNLRA AIKS
靶标信息
TLR2 is a member of the Toll-like receptor (TLR) family which play a fundamental role in pathogen recognition and activation of innate immunity. TLR proteins act through adaptor molecules such as MyD88 and TIRAP to activate various kinases and transcription factors such as Protein Kinase C (PKC) alpha/beta and NF-kappa-B. TLR2 can form heterodimers with either TLR1 or TLR6, and as a heterodimer, can recognize a variety of bacterial and mycoplasma lipoproteins respectively. TLRs are highly conserved from Drosophila to humans and share structural and functional similarities. The various TLRs exhibit different patterns of expression. TLR2 is expressed most abundantly in peripheral blood leukocytes, and mediates host response to Gram-positive bacteria and yeast via stimulation of NF-kappaB. TLR2 aids in the recognition of pathogen-associated molecular patterns (PAMPs) that are expressed on infectious agents, and mediate the production of cytokines necessary for the development of effective immunity. Ten human homologs of TLRs (TLR1-10) have been described. TLR2 is expressed in human cells such as tonsils, microglia, lymph nodes, and appendices, activated B-cells in germinal centers. CD14+ monocytes express the highest level of TLR2 followed by CD15+ granulocytes, CD19+ B-cells, and CD3+ T-cells. The expression of TLR2 on different cell types are regulated by different immune response modifiers. For example, LPS, GM-CSF, IL-1, and IL-10 up regulates TLR2 whereas IL-4, IFN-gamma, and TNF down regulate TLR2 expression in monocytes.
仅用于科研。不用于诊断过程。未经明确授权不得转售。
篇参考文献 (0)
生物信息学
蛋白别名: CD282; TLR-2; Toll-like receptor 2; Toll/interleukin-1 receptor-like protein 4
基因别名: TIL4; TLR2
Entrez Gene ID: (Human) 7097